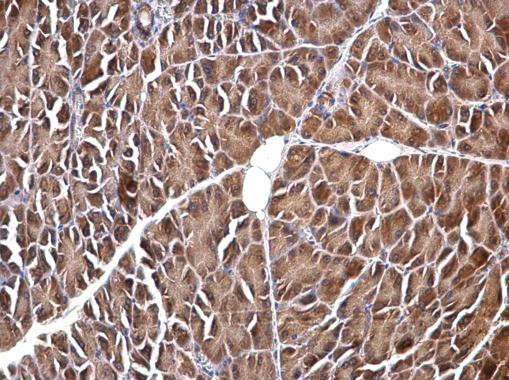
VIP Antibody in Immunohistochemistry (Paraffin) (IHC (P))

Search
Invitrogen
VIP Polyclonal Antibody
{{$productOrderCtrl.translations['antibody.pdp.commerceCard.promotion.promotions']}}
{{$productOrderCtrl.translations['antibody.pdp.commerceCard.promotion.viewpromo']}}
{{$productOrderCtrl.translations['antibody.pdp.commerceCard.promotion.promocode']}}: {{promo.promoCode}} {{promo.promoTitle}} {{promo.promoDescription}}. {{$productOrderCtrl.translations['antibody.pdp.commerceCard.promotion.learnmore']}}
图: 1 / 7
VIP Antibody (PA5-78224) in IHC (P)







产品信息
PA5-78224
种属反应
已发表种属
宿主/亚型
分类
类型
抗原
偶联物
形式
浓度
规格
纯化类型
保存液
内含物
保存条件
运输条件
RRID
产品详细信息
Positive Control: SK-N-SH , SK-N-AS, PC-3
Predicted Reactivity: Pig (100%), Sheep (100%), Rhesus Monkey (100%), Bovine (100%)
Store product as a concentrated solution. Centrifuge briefly prior to opening the vial.
靶标信息
VIP encodes a protein that belongs to the glucagon family. It stimulates myocardial contractility, causes vasodilation, increases glycogenolysis, lowers arterial blood pressure and relaxes the smooth muscle of trachea, stomach and gall bladder. Alternative splicing occurs at this locus and two transcript variants encoding distinct isoforms have been identified.
仅用于科研。不用于诊断过程。未经明确授权不得转售。
生物信息学
蛋白别名: MGC13587; PACAP-R-2; PHI, peptide histidine isoleucine; prepro-VIP; unnamed protein product; vasoactive intestinal peptide (VIP) precursor; vasoactive intestinal polypeptide; VIP peptides; VIP-R-1
基因别名: PHM27; VIP; vip/phi27
UniProt ID: (Human) P01282, (Rat) P01283, (Mouse) P32648
Entrez Gene ID: (Human) 7432, (Rat) 117064, (Mouse) 22353